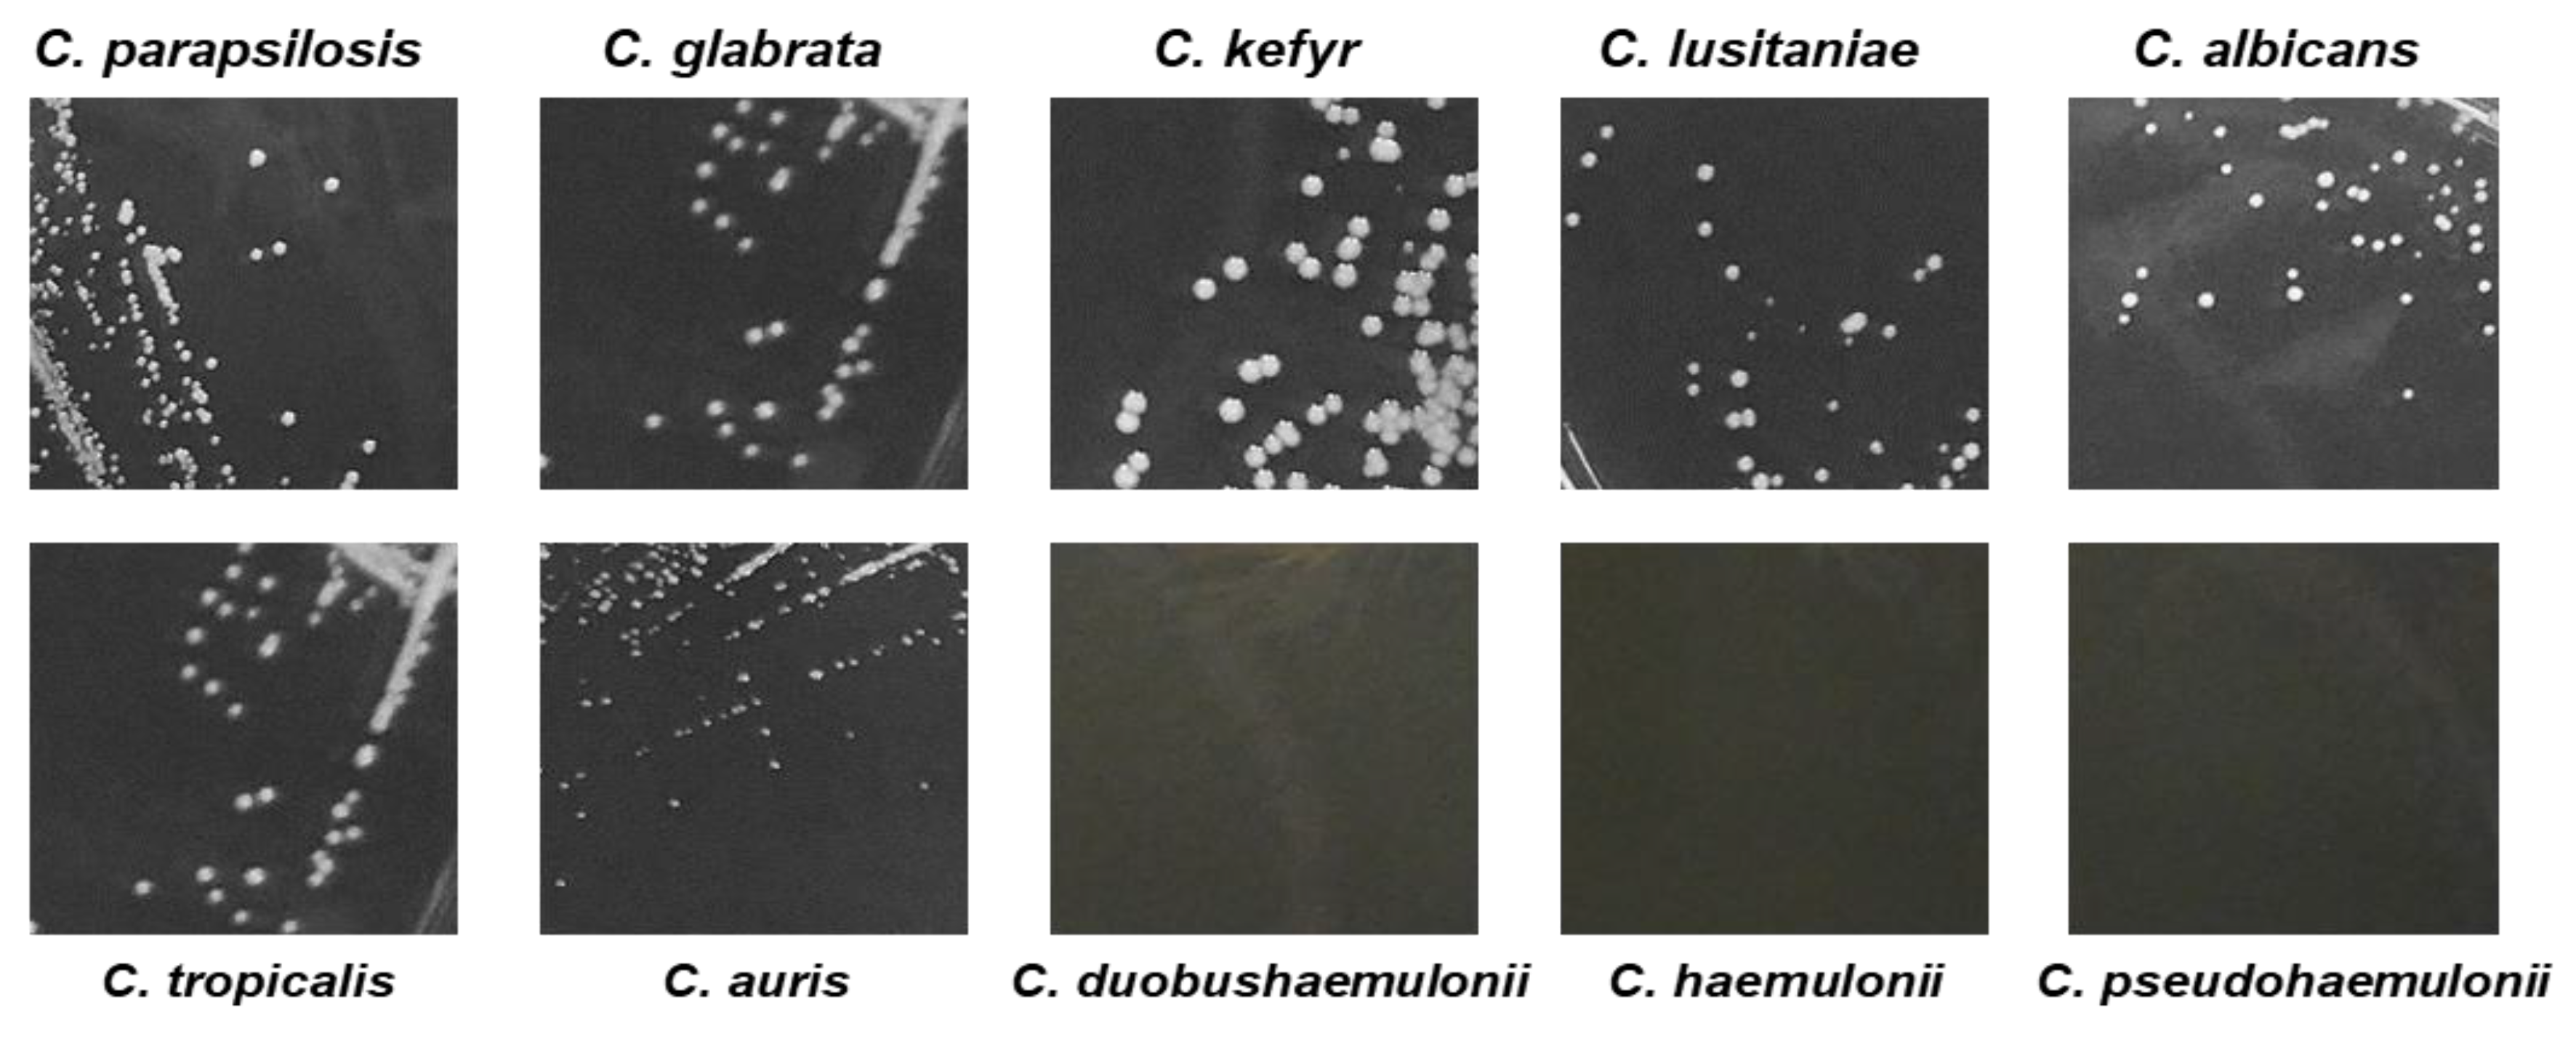
Jof 05 00103 g003 Jof 05 00103 g003

Thermogenic Characterization and Antifungal Susceptibility of Candida auris by Microcalorimetry
Abstract
1. Introduction
2. Materials and Methods
2.1. Candida Strains and Growth Conditions
2.2. Antimicrobial Agents
2.3. Biofilm Formation on Porous Glass Beads
2.4. Characterization and Antifungal Assay by Isothermal Microcalorimetry (IMC)
2.5. Data Analysis
3. Results
3.1. Microcalorimetric Analysis of Candida spp.
3.2. Analysis of Candida spp. Growth on Solid Medium
3.3. Analysis of C. auris Biofilm Formation
3.4. Susceptibility Assay of Planktonic and Biofilm-embedded C. auris to Amphotericin B and Fluconazole by IMC
4. Discussion
Author Contributions
Funding
Conflicts of Interest
References
- Chowdhary, A.; Sharma, C.; Meis, J.F. Candida auris: A rapidly emerging cause of hospital-acquired multidrug-resistant fungal infections globally. PLoS Pathog. 2017, 13, e1006290. [Google Scholar] [CrossRef] [PubMed]
- Meis, J.F.; Chowdhary, A. Candida auris: A global fungal public health threat. Lancet Infect. Dis. 2018, 18, 1298–1299. [Google Scholar] [CrossRef]
- Arikan-Akdagli, S.; Ghannoum, M.; Meis, J.F. Antifungal resistance: Specific focus on multidrug resistance in Candida auris and secondary azole resistance in Aspergillus fumigatus. J. Fungi 2018, 4, 129. [Google Scholar] [CrossRef] [PubMed]
- Chowdhary, A.; Prakash, A.; Sharma, C.; Kordalewska, M.; Kumar, A.; Sarma, S.; Tarai, B.; Singh, A.; Upadhyaya, G.; Upadhyay, S.; et al. A multicentre study of antifungal susceptibility patterns among 350 Candida auris isolates (2009–2017) in India: Role of the ERG11 and FKS1 genes in azole and echinocandin resistance. J. Antimicrob. Chemother. 2018, 73, 891–899. [Google Scholar] [CrossRef] [PubMed]
- Rhodes, J.; Fisher, M.C. Global epidemiology of emerging Candida auris. Curr. Opin. Microbiol. 2019, 52, 84–89. [Google Scholar] [CrossRef]
- Kean, R.; Ramage, G. Combined antifungal resistance and biofilm tolerance: The global threat of Candida auris. mSphere 2019, 4. [Google Scholar] [CrossRef]
- Kean, R.; Delaney, C.; Sherry, L.; Borman, A.; Johnson, E.M.; Richardson, M.D.; Rautemaa-Richardson, R.; Williams, C.; Ramage, G. Transcriptome Assembly and profiling of Candida auris reveals novel insights into biofilm-mediated resistance. mSphere 2018, 3, e00334-18. [Google Scholar] [CrossRef]
- Singh, R.; Kaur, M.; Chakrabarti, A.; Shankarnarayan, S.A.; Rudramurthy, S.M. Biofilm formation by Candida auris isolated from colonising sites and candidemia cases. Mycoses 2019, 62, 706–709. [Google Scholar] [CrossRef]
- Sherry, L.; Ramage, G.; Kean, R.; Borman, A.; Johnson, E.M.; Richardson, M.D.; Rautemaa-Richardson, R. Biofilm-forming capability of highly virulent, multidrug-resistant Candida auris. Emerg. Infect. Dis. 2017, 23, 328–331. [Google Scholar] [CrossRef]
- Roberts, S.C.; Zembower, T.R.; Bolon, M.K.; Kadakia, A.R.; Gilley, J.H.; Ko, J.H.; Clark, J.; Ward-Fore, S.; Taiwo, B.O. Successful treatment of a Candida auris intra-articular infection. Emerg. Microbes Infect. 2019, 8, 866–868. [Google Scholar] [CrossRef]
- Kenters, N.; Kiernan, M.; Chowdhary, A.; Denning, D.W.; Peman, J.; Saris, K.; Schelenz, S.; Tartari, E.; Widmer, A.; Meis, J.F.; et al. Control of Candida auris in healthcare institutions: Outcome of an International Society for Antimicrobial Chemotherapy expert meeting. Int. J. Antimicrob. Agents 2019, 54, 400–406. [Google Scholar] [CrossRef] [PubMed]
- Satoh, K.; Makimura, K.; Hasumi, Y.; Nishiyama, Y.; Uchida, K.; Yamaguchi, H. Candida auris sp. nov., a novel ascomycetous yeast isolated from the external ear canal of an inpatient in a Japanese hospital. Microbiol. Immunol. 2009, 53, 41–44. [Google Scholar] [CrossRef] [PubMed]
- Kathuria, S.; Singh, P.K.; Sharma, C.; Prakash, A.; Masih, A.; Kumar, A.; Meis, J.F.; Chowdhary, A. Multidrug-Resistant Candida auris Misidentified as Candida haemulonii: Characterization by Matrix-Assisted Laser Desorption Ionization-Time of Flight Mass Spectrometry and DNA Sequencing and Its Antifungal Susceptibility Profile Variability by Vitek 2, CLSI Broth Microdilution, and Etest Method. J. Clin. Microbiol. 2015, 53, 1823–1830. [Google Scholar] [CrossRef] [PubMed]
- Dewaele, K.; Lagrou, K.; Frans, J.; Hayette, M.P.; Vernelen, K. Hospital Laboratory Survey for Identification of Candida auris in Belgium. J. Fungi 2019, 5, 84. [Google Scholar] [CrossRef]
- Buil, J.B.; van der Lee, H.A.; Curfs-Breuker, I.; Verweij, P.E.; Meis, J.F. External quality assessment evaluating the ability of Dutch clinical microbiological laboratories to identify Candida auris. J. Fungi 2019, 5, 94. [Google Scholar] [CrossRef]
- Butini, M.E.; Gonzalez Moreno, M.; Czuban, M.; Koliszak, A.; Tkhilaishvili, T.; Trampuz, A.; Di Luca, M. Real-time antimicrobial susceptibility assay of planktonic and biofilm bacteria by isothermal microcalorimetry. Adv. Exp. Med. Biol. 2018. [Google Scholar] [CrossRef]
- Braissant, O.; Wirz, D.; Bachmann, A. Microbial growth and isothermal microcalorimetry: Growth models and their application to microcalorimetric data. Thermochim. Acta 2013, 555, 64–71. [Google Scholar] [CrossRef]
- Butini, M.E.; Cabric, S.; Trampuz, A.; Di Luca, M. In vitro anti-biofilm activity of a biphasic gentamicin-loaded calcium sulfate/hydroxyapatite bone graft substitute. Coll. Surf. B Biointerfaces 2018, 161, 252–260. [Google Scholar] [CrossRef]
- Czuban, M.; Srinivasan, S.; Yee, N.A.; Agustin, E.; Koliszak, A.; Miller, E.; Khan, I.; Quinones, I.; Noory, H.; Motola, C.; et al. Bio-orthogonal chemistry and reloadable biomaterial enable local activation of antibiotic prodrugs and enhance treatments against Staphylococcus aureus infections. ACS Cent. Sci. 2018, 4, 1624–1632. [Google Scholar] [CrossRef]
- Gonzalez Moreno, M.; Trampuz, A.; Di Luca, M. Synergistic antibiotic activity against planktonic and biofilm-embedded Streptococcus agalactiae, Streptococcus pyogenes and Streptococcus oralis. J. Antimicrob. Chemother. 2017, 72, 3085–3092. [Google Scholar] [CrossRef]
- Gonzalez Moreno, M.; Wang, L.; De Masi, M.; Winkler, T.; Trampuz, A.; Di Luca, M. In vitro antimicrobial activity against Abiotrophia defectiva and Granulicatella elegans biofilms. J. Antimicrob. Chemother. 2019, 74, 2261–2268. [Google Scholar] [CrossRef] [PubMed]
- Butini, M.E.; Abbandonato, G.; Di Rienzo, C.; Trampuz, A.; Di Luca, M. Isothermal microcalorimetry detects the presence of persister cells in a Staphylococcus aureus biofilm after vancomycin treatment. Front. Microbiol. 2019, 10, 332. [Google Scholar] [CrossRef] [PubMed]
- Tkhilaishvili, T.; Di Luca, M.; Abbandonato, G.; Maiolo, E.M.; Klatt, A.B.; Reuter, M.; Moncke-Buchner, E.; Trampuz, A. Real-time assessment of bacteriophage T3-derived antimicrobial activity against planktonic and biofilm-embedded Escherichia coli by isothermal microcalorimetry. Res. Microbiol. 2018, 169, 515–521. [Google Scholar] [CrossRef] [PubMed]
- Tkhilaishvili, T.; Lombardi, L.; Klatt, A.B.; Trampuz, A.; Di Luca, M. Bacteriophage Sb-1 enhances antibiotic activity against biofilm, degrades exopolysaccharide matrix and targets persisters of Staphylococcus aureus. Int. J. Antimicrob. Agents 2018, 52, 842–853. [Google Scholar] [CrossRef]
- Czuban, M.; Wulsten, D.; Wang, L.; Di Luca, M.; Trampuz, A. Release of different amphotericin B formulations from PMMA bone cements and their activity against Candida biofilm. Coll. Surf. B Biointerfaces 2019, 183, 110406. [Google Scholar] [CrossRef]
- Chow, N.A.; de Groot, T.; Badali, H.; Abastabar, M.; Chiller, T.M.; Meis, J.F. Potential fifth clade of Candida auris, Iran, 2018. Emerg. Infect. Dis. 2019, 25, 1780–1781. [Google Scholar] [CrossRef]
- Maiolo, E.M.; Furustrand Tafin, U.; Borens, O.; Trampuz, A. Activities of fluconazole, caspofungin, anidulafungin, and amphotericin B on planktonic and biofilm Candida species determined by microcalorimetry. Antimicrob. Agents Chemother. 2014, 58, 2709–2717. [Google Scholar] [CrossRef]
- Trampuz, A.; Piper, K.E.; Jacobson, M.J.; Hanssen, A.D.; Unni, K.K.; Osmon, D.R.; Mandrekar, J.N.; Cockerill, F.R.; Steckelberg, J.M.; Greenleaf, J.F.; et al. Sonication of removed hip and knee prostheses for diagnosis of infection. N. Engl. J. Med. 2007, 357, 654–663. [Google Scholar] [CrossRef]
- Ravn, C.; Ferreira, I.S.; Maiolo, E.; Overgaard, S.; Trampuz, A. Microcalorimetric detection of staphylococcal biofilm growth on various prosthetic biomaterials after exposure to daptomycin. J. Orthop. Res. 2018, 36, 2809–2816. [Google Scholar] [CrossRef]
- Howell, M.; Wirz, D.; Daniels, A.U.; Braissant, O. Application of a microcalorimetric method for determining drug susceptibility in mycobacterium species. J. Clin. Microbiol. 2012, 50, 16–20. [Google Scholar] [CrossRef]
- Quindos, G.; Marcos-Arias, C.; San-Millan, R.; Mateo, E.; Eraso, E. The continuous changes in the aetiology and epidemiology of invasive candidiasis: From familiar Candida albicans to multiresistant Candida auris. Int. Microbiol. 2018, 21, 107–119. [Google Scholar] [CrossRef] [PubMed]
- Eyre, D.W.; Sheppard, A.E.; Madder, H.; Moir, I.; Moroney, R.; Quan, T.P.; Griffiths, D.; George, S.; Butcher, L.; Morgan, M.; et al. A Candida auris outbreak and its control in an intensive care setting. N. Engl. J. Med. 2018, 379, 1322–1331. [Google Scholar] [CrossRef] [PubMed]
- Meis, J.F.; Voss, A. Candida auris in an Intensive Care Setting. N. Engl. J. Med. 2019, 380, 890–891. [Google Scholar] [CrossRef] [PubMed]
- Chowdhary, A.; Sharma, C.; Duggal, S.; Agarwal, K.; Prakash, A.; Singh, P.K.; Jain, S.; Kathuria, S.; Randhawa, H.S.; Hagen, F.; et al. New clonal strain of Candida auris, Delhi, India. Emerg. Infect. Dis. 2013, 19, 1670–1673. [Google Scholar] [CrossRef] [PubMed]
- Ruiz-Gaitan, A.; Moret, A.M.; Tasias-Pitarch, M.; Aleixandre-Lopez, A.I.; Martinez-Morel, H.; Calabuig, E.; Salavert-Lleti, M.; Ramirez, P.; Lopez-Hontangas, J.L.; Hagen, F.; et al. An outbreak due to Candida auris with prolonged colonisation and candidaemia in a tertiary care European hospital. Mycoses 2018, 61, 498–505. [Google Scholar] [CrossRef] [PubMed]
- Casadevall, A.; Kontoyiannis, D.P.; Robert, V. On the Emergence of Candida auris: Climate change, azoles, swamps, and birds. mBio 2019, 10. [Google Scholar] [CrossRef]
- Jackson, B.R.; Chow, N.; Forsberg, K.; Litvintseva, A.P.; Lockhart, S.R.; Welsh, R.; Vallabhaneni, S.; Chiller, T. On the origins of a species: What might explain the rise of Candida auris? J. Fungi 2019, 5, 58. [Google Scholar] [CrossRef]
- Di Luca, M.; Navari, E.; Esin, S.; Menichini, M.; Barnini, S.; Trampuz, A.; Casani, A.; Batoni, G. Detection of Biofilms in Biopsies from Chronic Rhinosinusitis Patients: In vitro biofilm forming ability and antimicrobial susceptibility testing in biofilm mode of growth of isolated bacteria. Adv. Exp. Med. Biol. 2018, 1057, 1–27. [Google Scholar] [CrossRef]
- Grassi, L.; Di Luca, M.; Maisetta, G.; Rinaldi, A.C.; Esin, S.; Trampuz, A.; Batoni, G. Generation of Persister Cells of Pseudomonas aeruginosa and Staphylococcus aureus by chemical treatment and evaluation of their susceptibility to membrane-targeting agents. Front. Microbiol. 2017, 8, 1917. [Google Scholar] [CrossRef]
- Lockhart, S.R.; Etienne, K.A.; Vallabhaneni, S.; Farooqi, J.; Chowdhary, A.; Govender, N.P.; Colombo, A.L.; Calvo, B.; Cuomo, C.A.; Desjardins, C.A.; et al. Simultaneous emergence of multidrug-resistant Candida auris on 3 continents confirmed by whole-genome sequencing and epidemiological analyses. Clin. Infect. Dis. 2017, 64, 134–140. [Google Scholar] [CrossRef]
- Arendrup, M.C.; Prakash, A.; Meletiadis, J.; Sharma, C.; Chowdhary, A. Comparison of EUCAST and CLSI Reference Microdilution MICs of Eight Antifungal Compounds for Candida auris and Associated Tentative Epidemiological Cutoff Values. Antimicrob. Agents Chemother. 2017, 61. [Google Scholar] [CrossRef] [PubMed]

| Strains | 1FLC | 2VRC | 3AMB | 4CAS | 55FC | 6MFG | 7ITC | 8POS | 9AFG | 10ISA |
|---|---|---|---|---|---|---|---|---|---|---|
| C. lusitaniae (L-719) | ≤0.5 | ≤0.12 | 0.5 | 0.25 | 2 | 0.25 | 0.012 | 0.004 | 0.16 | 0.004 |
| C. kefyr (K-629) | 1 | ≤0.12 | 1 | ≤0.12 | 4 | 0.12 | 0.023 | 0.023 | 0.12 | 0.004 |
| C. tropicalis (T 317) | 1 | ≤0.12 | 0.5S | ≤0.12 | ≤1 | ≤0.06 | 0.012 | 0.008 | 0.008 | 0.006 |
| C. haemulonii (H 433) | 2 | ≤0.12 | ≥16 | 0.25 | ≤1 | 0.25 | n.a. | n.a. | 0.5 | n.a. |
| C. duobushaemulonii (D-437) | 2 | ≤0.12 | 2 | ≤0.12 | ≤1 | ≤0.06 | n.a. | n.a. | 0.032 | n.a. |
| C. pseudohaemulonii (P-430) | n.a. | n.a. | n.a. | n.a. | n.a. | n.a. | n.a. | n.a. | n.a. | n.a. |
| C. auris 10051257(467/P/14) | 32 | 2 | 1.5 | ≥8 | ≤1 | ≥8 | 1 | 0.25 | ≥8 | 0.5 |
| C. auris 10051259(471/P/14) | 32 | 1 | 1 | 0.25 | ≤1 | 0.125 | 2 | 038 | 0.064 | 1 |
| C. auris 10051266(1113/P/13) | 32 | 1 | 1 | ≥8 | ≤1 | ≥8 | 1 | 0.25 | 32 | 0.5 |
| C. auris 10051297(550/P/14) | 32 | 2 | 8 | ≥8 | ≥64 | ≥8 | 2 | 0.125 | 8 | 0.25 |
| C. auris CBS14916 | 32 | 0.25 | 8 | 0.25 | ≥64 | 0.12 | 0.064 | 0.032 | 0.125 | 0.032 |
| Strains | Pmax (μW) 1 | Tmax (h) 2 | Htot (J) 3 | TTD (h) 4 | λ (h) 5 | (μ, J/h) 6 |
|---|---|---|---|---|---|---|
| C. parapsilosis ATCC 22019 | 195.3 | 6.89 | 4.86 | 1.79 | 5.06 | 1.04 |
| C. glabrata DSY 562 | 168.4 | 6.54 | 4.71 | 1.05 | 3.96 | 0.60 |
| C. kefyr (K-629) | 145.1 | 6.54 | 5.60 | 1.01 | 4.00 | 0.52 |
| C. lusitaniae (L-719) | 112.3 | 9.31 | 4.90 | 1.01 | 5.14 | 0.40 |
| C. albicans ATCC 90028 | 108.1 | 10.91 | 5.02 | 1.01 | 5.69 | 0.38 |
| C. auris CBS14916 | 65.1 | 17.07 | 5.27 | 1.01 | 5.19 | 0.23 |
| C. tropicalis (T 317) | 80.3 | 13.98 | 8.49 | 1.01 | 5.51 | 0.28 |
| C. duobushaemulonii (D-437) | 29.5 | 46.00 | 3.46 | 1.69 | 21.99 | 0.18 |
| C. haemulonii (H 433) | 23.9 | 46.00 | 3.15 | 7.21 | 17.64 | 0.16 |
| C. pseudohaemulonii (P-430) | 25.4 | 46.00 | 2.91 | 2.50 | 20.94 | 0.14 |
| Strains | 25 °C | 30 °C | 37 °C | ||||||
|---|---|---|---|---|---|---|---|---|---|
| 24 h | 48 h | 72 h | 24 h | 48 h | 72 h | 24 h | 48 h | 72 h | |
| C. parapsilosis ATCC 22019 | n.g 1. | 1 | 2 | 0.5 | 1–2 | 3 | 1 | 2 | 3 |
| C. glabrata DSY 562 | n.g. | 1 | 2 | 0.5 | 2 | 3 | 1 | 2 | 3 |
| C. kefyr (K-629) | n.g. | 1 | 2 | 0.5 | 1 | 1–2 | 1 | 2–3 | 3 |
| C. lusitaniae (L-719) | n.g. | 0.5 | 1 | 0.5 | 1 | 1 | 0.5 | 1–2 | 2 |
| C. albicans ATCC 90028 | n.g. | 0.5 | 1 | 0.5 | 1–2 | 2 | 0.5 | 1–2 | 2 |
| C. auris CBS14916 | n.g. | <0.5 | 1 | <0.5 | 1 | 1 | 0.5 | 1–2 | 3 |
| C. tropicalis (T 317) | n.g. | 1 | 2 | 0.5 | 1 | 1 | 1 | 1–2 | 2 |
| C. duobushaemulonii (D-437) | n.g. | <0.5 | 1 | n.g. | n.g. | n.g. | n.g. | 0.5 | 1 |
| C. haemulonii (H 433) | n.g. | 0.5 | 1 | 0.5 | 0.5 | 1 | n.g. | <0.5 | 0.5 |
| C. pseudohaemulonii (P-430) | n.g. | 0.5 | 1 | <0.5 | 0.5 | 0.5 | n.g | <0.5 | 1 |
| Strains | IMC 1 | Plating | ||||||
|---|---|---|---|---|---|---|---|---|
| Planktonic | Biofilm | Planktonic | Biofilm | |||||
| MHIC 2 | MBFC 3 | MFC 4 | MBEC 5 | |||||
| AMB 6 | FLC7 | AMB | FLC | AMB | FLC | AMB | FLC | |
| C. auris 10051257 | 0.5 | >128 | 8 | >256 | 1 | >128 | 8 | >256 |
| C. auris 10051259 | 0.5 | >128 | >8 | >256 | 1 | >128 | >8 | >256 |
| C. auris 10051266 | 0.5 | >128 | >8 | >256 | 1 | >128 | >8 | >256 |
| C. auris 10051297 | 0.5 | >128 | 8 | >256 | 1 | >128 | 8 | >256 |
| C. auris CBS14916 | 0.5 | >128 | n.a.8 | >256 | 0.5 | >128 | n.a. | >256 |
© 2019 by the authors. Licensee MDPI, Basel, Switzerland. This article is an open access article distributed under the terms and conditions of the Creative Commons Attribution (CC BY) license (http://creativecommons.org/licenses/by/4.0/).
Share and Cite
Di Luca, M.; Koliszak, A.; Karbysheva, S.; Chowdhary, A.; Meis, J.F.; Trampuz, A. Thermogenic Characterization and Antifungal Susceptibility of Candida auris by Microcalorimetry. J. Fungi 2019, 5, 103. https://doi.org/10.3390/jof5040103
Di Luca M, Koliszak A, Karbysheva S, Chowdhary A, Meis JF, Trampuz A. Thermogenic Characterization and Antifungal Susceptibility of Candida auris by Microcalorimetry. Journal of Fungi. 2019; 5(4):103. https://doi.org/10.3390/jof5040103
Chicago/Turabian StyleDi Luca, Mariagrazia, Anna Koliszak, Svetlana Karbysheva, Anuradha Chowdhary, Jacques F. Meis, and Andrej Trampuz. 2019. "Thermogenic Characterization and Antifungal Susceptibility of Candida auris by Microcalorimetry" Journal of Fungi 5, no. 4: 103. https://doi.org/10.3390/jof5040103
APA StyleDi Luca, M., Koliszak, A., Karbysheva, S., Chowdhary, A., Meis, J. F., & Trampuz, A. (2019). Thermogenic Characterization and Antifungal Susceptibility of Candida auris by Microcalorimetry. Journal of Fungi, 5(4), 103. https://doi.org/10.3390/jof5040103

